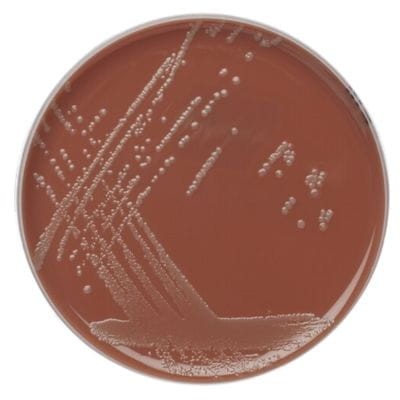
Chocolate Agar with Vitox gotowa pożywka na płytkach

Znaleziono produktów: 287
Chocolate Agar with Vitox gotowa pożywka na płytkach
• Opakowanie: 10 szt.
• Płytka: 90 mm.
• Wyrób medyczny: Tak
Chromogenic Coliform Agar gotowa pożywka do oznaczania Escherichia coli

Opakowanie - 10 szt.
Płytki - 90 mm.
Do oznaczania : Escherichia coli i bakterii z grupy coli
CLED Medium gotowa pożywka na płytkach do wykrywania powszechnych patogenów dróg moczowych

• Opakowanie: 10 szt.
• Płytka: 90 mm.
• Wyrób medyczny: Tak
Zdjęcie ma charakter poglądowy.
Columbia Agar with Sheep Blood PLUS gotowa pożywka z krwią owczą do hemolizy

• Opakowanie: 10 szt
• Płytka: 90 mm
• Podłoże z krwią owczą
• Wyrób medyczny: Tak
Columbia CNA STAPH/STREP gotowa pożywka na płytkach Petriego

• Opakowanie: 10 szt.
• Płytka: 90 mm.
• Do izolowania organizmów Gram-dodatnich.
D/E Neutralizing Broth

• Opakowanie: 500 g.
Dermasel Selective Medium gotowa pożywka na płytkach do izolacji grzybów dermatofitowych

• Opakowanie: 10 szt.
• Płytka: 90 mm.
• Do izolacji grzybów dermatofitowych.
• Wyrób medyczny: Tak.
Dermatophytes Selective Agar (Taplin) gotowa pożywka na płytkach do odróżniania dermatofitów od innych grzybów

• Opakowanie: 10 szt.
• Płytka: 90 mm.
• Do odróżniania dermatofitów od innych grzybów.
• Wyrób medyczny: Tak.
Dichloran Rose-Bengal Chloramphenicol Medium gotowa pożywka na płytkach

• Opakowanie: 10 szt.
• Płytka: 90 mm.
• Do oznaczania drożdży i pleśni
Dichloran-Glycerol (DG18) Selective Medium gotowa pożywka na płytkach

• Opakowanie: 10 szt.
• Płytka: 90 mm.
• Do oznaczania drożdży i pleśni.
Dryspot Staphytect Plus Kit test lateksowy

• Identyfikacja i różnicowanie Staphylococcus aureus
• Opakowanie: 120 szt.
• Wyrób medyczny: Tak
Dyspenser do nanoszenia krążków antybiotykowych 6 pozycyjny

• Kompatybilność: Do użytku wyłącznie z krążkami Oxoid
• Liczba miejsc: 6 miejsc
• Wyrób medyczny: Tak
darmowa i wygodna wysyłka
już od 800 zł netto
Najwyższa jakość
produktów potwierdzona certyfikatami
Zakupy 24h na dobę
wygodne i bezpieczne
bezpłatna konsultacja
z ekspertem online

